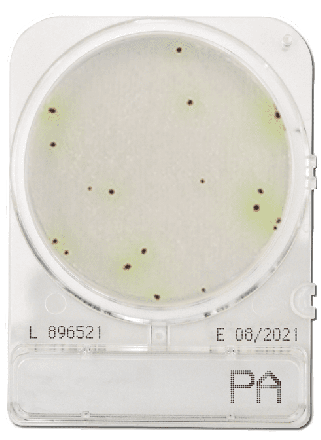
Compact Dry PA Pseudomonas aeruginosa
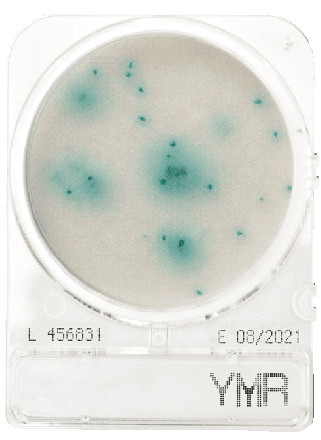
Compact Dry YMR (rapid) Yeast and mould
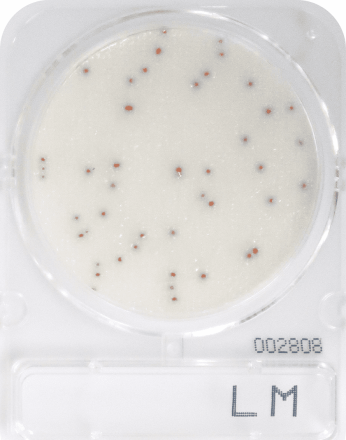
Compact Dry LM Listeria monocytogenes
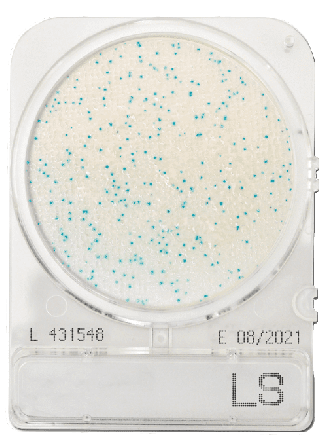
Compact Dry LS Listeria species
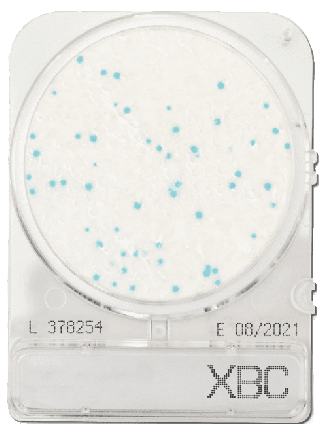
Compact Dry XBC (BC) Bacillus cereus
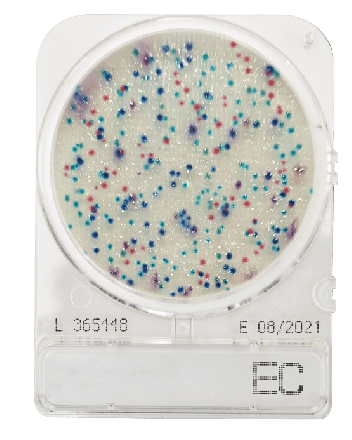
Compact Dry EC E. coli and coliform

- Strona Główna
- Mikrobiologia
Mikrobiologia
Sprzęt i odczynniki do analiz mikrobiologicznych, w tym podłoża hodowlane, pożywki, odczynniki diagnostyczne oraz systemy do identyfikacji drobnoustrojów. Idealne do badań laboratoryjnych i kontroli jakości.
Mikrobiologia | Odczynniki, podłoża, testy, akcesoria
Zobacz jako Siatka Lista
Produkty 1-12 z 17
Strona
- Aktualnie czytasz stronę 1
- Strona 2
- Strona Następne
-
Compact Dry PA Pseudomonas aeruginosa
Specjalne płytki do detekcji P. aeruginosa – patogenu oportunistycznego.
-
Compact Dry YMR (rapid) Yeast and mould
Szybka analiza drożdży i pleśni (przyspieszony okres inkubacji).
-
-
-
-
Compact Dry AQ Heterotrophic bacteria in water
Gotowe płytki do oznaczania bakterii heterotroficznych (HPC) w wodzie.
-
-
Zobacz jako Siatka Lista
Produkty 1-12 z 17
Strona
- Aktualnie czytasz stronę 1
- Strona 2
- Strona Następne
Filtruj produkty
Opcje zakupów
Producent
Cena